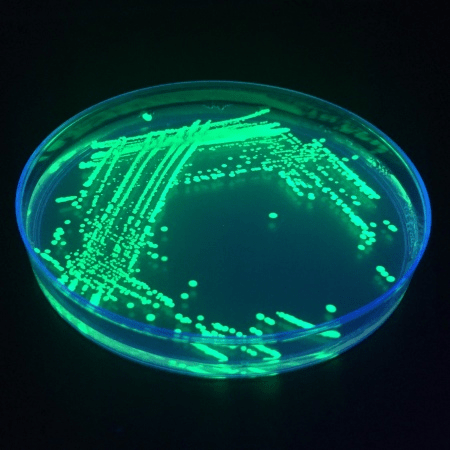

Most people think of our DNA as solely a molecular structure that chemically codes for making the components of our body.

However, research is now demonstrating that it is much more than that – it is also a transmitter of signals that carry information. With the fairly recent decoding of DNA in our genes via the Human Genomic Project, scientists thought that now we will have a “full” understanding of life as dictated by our genes.
Unfortunately, the number of genes that we possess is not that different than most living organisms – i.e., we are not so “special”. Humans have about 23,000 genes, about the same number as found in mice and earthworms.

But we did have a lot of “junk” DNA that scientists did not understand since they were not the genes that coded for the proteins and enzymes that make up and build the body (hence, the term “junk”).
We are now beginning to understand that the “junk” DNA appears to act as regulators that control the information that affects the operation of our body and hence its health.
This understanding is creating a new field called epigenetics.

It also appears that our intentions and thoughts become control knobs for changing the channel for the DNA signal! Light originating from our cells (biophotons) and electromagnetic signals appear to be involved in the signaling process.
I will now briefly outline some of the scientific underpinnings that support this new look at the role of the DNA molecule.
Structured proton presence persists after the DNA is gone
Dr. Peter Gariaev, Director of Wave Genetics in Russia, performed an amazing experiment.

When DNA, under vacuum, is exposed to a mild laser light, a sensitive photomultiplier instrument can pick up the signals from the DNA.
When the DNA is removed from the container that held the DNA, the photomultiplier still picks up a structured photon presence and does so for about 30 days (the “phantom DNA effect”).
Standard science says this cannot occur. Since it does occur, the DNA has structured the photons in this space, i.e., established a pattern in the field.
This experiment gives us insight into the mechanism of messaging using DNA…
DNA instructions carried by light
Related to the Phantom DNA story are other stories in which signals are used to carry out the action of DNA.
Dr. Vlail Kaznacheyev, Director of the Institute for Clinical and Experimental Medicine in Novosibirsk, showed that a virus can be transmitted from one culture plate to another using ultraviolet light.
Thus, information is being carried with photons that have been “structured” in one culture plate to another culture plate. Some Russian scientists believe that this effect is being carried out by “torsion” energy.
Dr. Dzang Kangeng in China showed that light passed through a duck into 500 chicken eggs resulting in chicks in which 80% had flat bills, 90% had eyes moved to a position similar to ducks and 25% had webbing between their toes.

Their offspring remained partial duck, partial chicken…
Dr. Gariaev directed green laser light through salamander eggs and then through frog eggs.
Salamanders hatched from the frog eggs…
He has coined the term “wave genetics.”
DNA fragments “regenerate” themselves
Nobel Laureate virologist, Dr. Luc Montagnier (who shared the prize for discovering the HIV virus) discovered the apparent ability of DNA fragments to “regenerate” themselves using an electromagnetic field.

Two separate tubes were placed in a copper coil and subjected to an electromagnetic field of 7 hertz.
One tube had a DNA fragment and the other tube just had pure water.
After 16 hours, the tubes were subjected to the polymerase chain reaction (PCR) to create replicants of the DNA (the standard technique that enzymatically makes many copies of DNA to enable measurement of DNA that is originally in a small quantity).
The DNA was found in the tube with just pure water.
The hypothesis is that the DNA structure is preserved and amplified through quantum coherence in the water tube and the PCR process mistakes it for the DNA itself.

What is the mechanism?
In order to gain some understanding of the mechanism involved and to see how consciousness plays into the effects, one can look at the work of Dr. Fritz-Albert Popp at the International Institute of Biophysics in Germany.
The hypothesis:
DNA interacts strongly with coherent laser light and affects the NH…O and NH…H hydrogen bonds.

Biophotons from all parts of the body are coherent (not random) and thus can allow communication. The machinery of each cell coordinates its activities by exchanging biophotons with other cells.
The organization occurs cooperatively using a pattern supplied by the DNA. The DNA acts like a photon store and will raise the energy levels of molecules, preparing them for a chemical reaction.

Consciousness may affect the non-local field (like a torsion/bioenergy field) which affect DNA which affects biophotons release which affects chemical reactions such as protein synthesis.
In another hypothesis, Dr. Keith Scott-Mumby, reviewing the above types of experiments in Virtual Medicine, describes “radio DNA” in which the DNA acts like an antenna transmitting information to carry out the activities of the cell.

The science of DNA and consciousness is a fascinating field; we are lucky to be observing this field in its infancy.
How distant healing might occur
With the above information, one can further hypothesize as to how distant healing can occur.

One cannot just use electromagnetic fields (e.g., light) since they reduce in strength with distance. For example, if one considers a torsion field interacting with the field of consciousness, then distal effects can occur.
The consciousness frequencies involved would interact with the DNA which transmits the information for chemical reactions.
Acknowledgments

The experiments described above, with references, can be found in Claude Swanson‘s Life Force: The Scientific Basis and Keith Scott-Mumby‘s Virtual Medicine.
by: Jerry Gin
